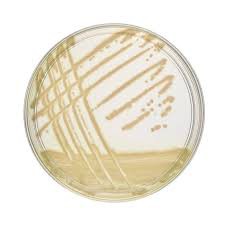

| Tên sản phẩm: | Pseudomonas CFC Selective Supplement |
| Code: | 1076270010 |
| Hãng – Xuất xứ: | Merck – Đức |
| Ứng dụng: |
– Hóa chất được sử dụng làm thuốc thử trong phân tích. Sử dụng trong phòng thí nghiệm trường học, viện nghiên cứu,… – Dùng để pha chế môi trường nuôi cấy phân lập nấm và vi khuẩn trong phân tích hóa sinh. |
| Tính chất: |
– Hình thể: rắn, màu trắng – Giá trị pH: 6,2 – 6,8 (26,2 g/l, H₂O, 20 °C) – Độ hòa tan: 26,6 g/l |
| Bảo quản: | Nhiệt độ lưu trữ từ +2°C đến +8°C. |
| Quy cách: | 10 lọ/ hộp |

Đánh giá
Chưa có đánh giá nào.